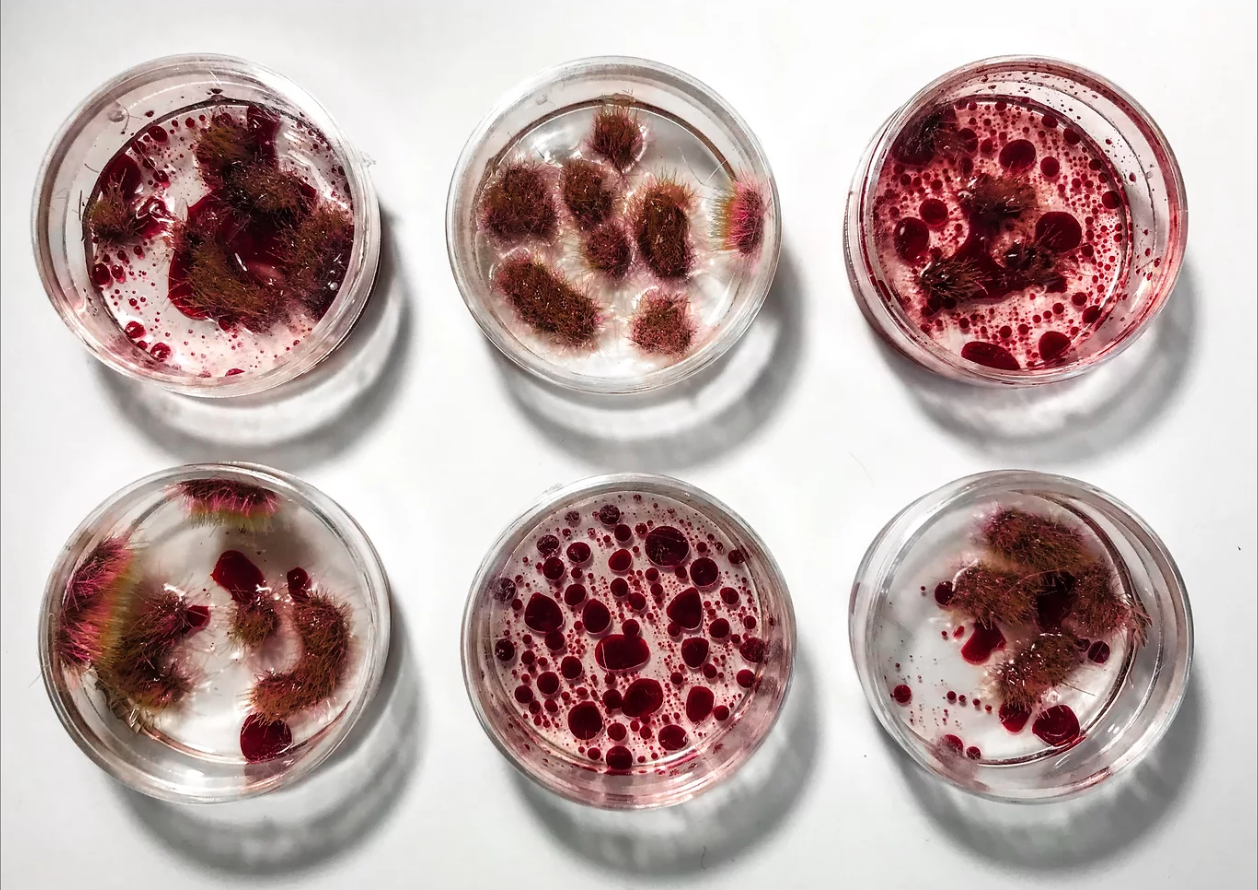
BIO SIMULATIONS (SNIPPET) | bacteria infected myocardial cells simulation

NATALIA MARIN
Independent Curator & SciArtist
“I’m Natalia and I create life out of life.
My passion for various branches of science confronted me with the artistically unexplored sides of humanity and paradoxically showed me how close technology is to nature, in form, essence and even functionality. He showed me that the spirit can be somehow shaped, transformed and even preserved through certain applications of art.
Although I work with life, my creations have no end. They materialize in exchange for emotion, in transient thoughts, which are implanted in the circuit of your mind and later give birth, through your hands, to new creations.
My art is not a finished product but a continuous network of ideas.
Energy does not appear, does not disappear, is preserved!”